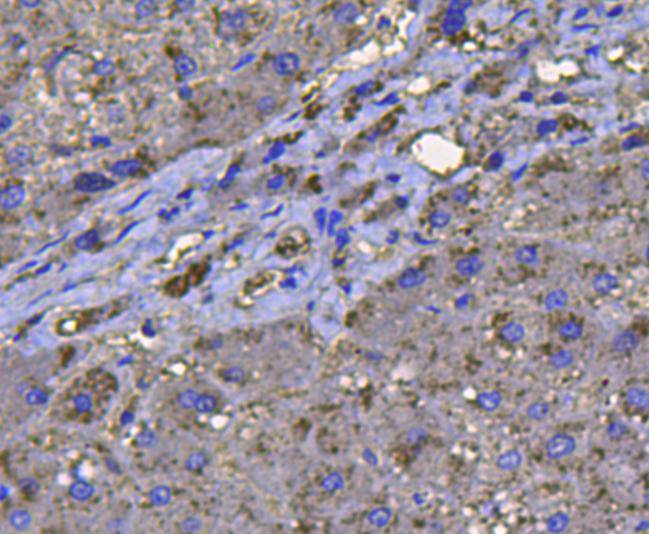
产品细节图片5

相关产品推荐更多 >
万千商家帮你免费找货
0 人在求购买到急需产品
- 详细信息
- 文献和实验
- 技术资料
- 免疫原:
Synthetic peptide (KLH-coupled) within human Caveolin-1 110-180aa.
- 形态:
liquid
- 保存条件:
Store at -20˚C
- 克隆性:
Polyclonal
- 适应物种:
Human;Mouse;Rat
- 保质期:
12 months
- 抗原来源:
Rabbit
- 供应商:
南京赛戈巍生物科技有限公司
- 宿主:
Rabbit
- 应用范围:
WB, ICC, IHC
- 靶点:
Uniprot:P04040
- 抗体英文名:
Catalase Antibody
- 规格:
50ul/100ul
CAT antibody
CATA_HUMAN antibody
Catalase antibody
Cs1 antibody
MGC138422 antibody
MGC138424 antibody
计算分子量:60 kDa
配方:1*TBS (pH7.4), 1%BSA, 40%Glycerol. Preservative: 0.05% Sodium Azide.
应用详情:WB: 1:1,000
IHC: 1:200
ICC: 1:200
图片:

Western blot analysis of Caveolin-1 on different lysates using anti-Caveolin-1 antibody at 1/500 dilution.
Positive control: Lane 1: F9 Lane 2: A549 Lane 3: Mouse lung Lane 4: Mouse liver Lane 5: Human lung Lane 6: Hela Lane 7: HepG2 Lane 8: Jurkat,

Immunohistochemical analysis of paraffin-embedded rat lung tissue using anti-catalase antibody. Counter stained with hematoxylin.
,

Immunohistochemical analysis of paraffin-embedded rat liver tissue using anti-catalase antibody. Counter stained with hematoxylin.
,

Immunohistochemical analysis of paraffin-embedded rat kidney tissue using anti-catalase antibody. Counter stained with hematoxylin.
,
Immunohistochemical analysis of paraffin-embedded human liver tissue using anti-catalase antibody. Counter stained with hematoxylin.
,

Immunohistochemical analysis of paraffin-embedded mouse liver tissue using anti-catalase antibody. Counter stained with hematoxylin.
,

Immunohistochemical analysis of paraffin-embedded mouse kidney tissue using anti-catalase antibody. Counter stained with hematoxylin.
,

ICC staining catalase in Hela cells (green). Cells were fixed in paraformaldehyde, permeabilised with 0.25% Triton X100/PBS.
,

ICC staining catalase in HepG2 cells (green). Cells were fixed in paraformaldehyde, permeabilised with 0.25% Triton X100/PBS.
风险提示:丁香通仅作为第三方平台,为商家信息发布提供平台空间。用户咨询产品时请注意保护个人信息及财产安全,合理判断,谨慎选购商品,商家和用户对交易行为负责。对于医疗器械类产品,请先查证核实企业经营资质和医疗器械产品注册证情况。
文献和实验14 Immunotargeting of Catalase to the Pulmonary Vascular Endothelium
. In order to provide catalase with such an affinity, catalase could be chemically conjugated with a carrier antibodies recognizing the surface endothelial antigens (8 ). A monoclonal antibody (MAb) against such an antigen, angiotensin-converting enzyme
here to measure the viability and relative fitness of bacteria in the presence of hydrogen peroxide. A protocol for the determination of catalase activity, an important part of the ROS detoxification process, is also described.
催化如下反应的酶: 2H2 O2 —→ 2H2 O O2 。 EC1. 11. 1. 6.另外在 H2 O2 、 CH3 COOH、 C2 H5 -OOH的存在下可将 C2 H5 OH、 CH3 OH、 CH3 CO- OH、 HCOOH、 HNO2 等氧化。因此,在 H2 O2 分解反应中实际上是一部分 H2 O2 分子作为电子供体,另一部分 H2 O2 分子作为电子受体而起反应。根据这一情况, H. Theorell对过
技术资料暂无技术资料 索取技术资料






![MMP2 Polyclonal Antibody RBITC Conjugated[C90175RBITC]](https://img1.dxycdn.com/p/s14/2025/0922/498/0460884283108299691.jpg!wh200)
![BCS1L Conjugated Antibody[C31919]](https://img1.dxycdn.com/p/s14/2025/0923/305/2150219664296040791.jpg!wh200)
![DUS2L Antibody[34081]](https://img1.dxycdn.com/p/s14/2025/0922/359/6146153295428599691.jpg!wh200)
![EDN1 Conjugated Antibody[C35735]](https://img1.dxycdn.com/p/s14/2025/0923/278/4431488150116040791.jpg!wh200)

